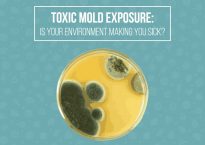

Dr. Jill Carnahan on “5 Benefits of Low-Dose Lithium”
Dr. Jill Carnahan wrote on an article on her blog called “A Little Lithium Goes a Long Way: Five Benefits of Low-Dose Lithium.” From the article:…

Dr. Jill Carnahan wrote on an article on her blog called “A Little Lithium Goes a Long Way: Five Benefits of Low-Dose Lithium.” From the article:…

Lauren Tessier, N.D., discussed topics related to treating mold-related illness in a Better Health Guy interview called “Beyond the Mold.” From the interview: What…

Dave Asprey of Bulletproof wrote an article titled “Ozone Therapy: What It Is and How It Works.” From the article: Normally, you hear about how damaging free radicals…

The Paradigm Change mold practitioners poll allows individuals participating in online mold groups to share information about which medical professionals have been helpful to them. This…

Ana Harris discusses her experiences attempting to make her mold and chemical sensitivities go away in an article called “My Brain Retraining Story” in her mold-oriented…

Holistic Primary Care published an article on “How To Help Patients Get the Most Out of Autumn Detox Protocols.” The article discusses modified citrus pectin,…

Gregory Muske wrote an article on the use of pine spirits for medicinal purposes for his blog Biotoxin Journey. From the article: Early medical volumes like the…

This project was conducted in the Mold Avoiders Facebook group in May 2018. A total of 111 people participated. The first poll question read: Are there any binders or…

This poll was conducted in the Bottoms Up Facebook group in March 2018. A total of 67 members participated. The group description is as follows: Bottoms Up is…

Bryan Rosner wrote an article called “Mold and Parasites” for his blog Bryan Rosner’s Anti-Lyme Journal. From the article: One interesting development in the “worm treating community”…

Kim Goodwin discussed options that individuals can consider if they do not achieve as much improvement as they would like to see as a result of…

Gregory Muske wrote an article called “Parasites and CIRS” for his blog Biotoxin Journey. From the article: For some time, I have been pursuing the parasite factor.…
Dr. Jay Davidson wrote a blog article called “What’s the Connection Between Toxic Mold and Lyme Disease?” From the article: One of the most significant issues that…

Jill Carnahan, M.D., wrote an article for her blog called “Boost Your DAO Levels To Fight Histamine.” From the article: Diamine oxidase (DAO) is…

Jill Carnahan, M.D., wrote an article for her blog called “Mold Is A Major Trigger of Mast Cell Activation Syndrome.” From the article: When…

Jill Carnahan, M.D., wrote an article for her blog called “The Sleeping Giant – Tips To Treat Reactivation of Epstein-Barr Virus.” From the article:…

This poll was conducted in the Mold Avoiders Facebook group in December 2017. A total of 158 members participated. The question and most frequent responses follow:…

Zach Bush, M.D., discussed “Gut Health and the Microbiome” in a video interview with Neurohacker collective. From the interview: I’ve come to realize that…

Gregory Muske of Biotoxin Journey has published a number of articles on therapies that he has explored in recovering from mold-related illness (also known as chronic inflammatory response…

This poll was conducted in the Mold Avoiders Facebook group in November 2017. The goal was to look at the reported health effects of MRI testing.